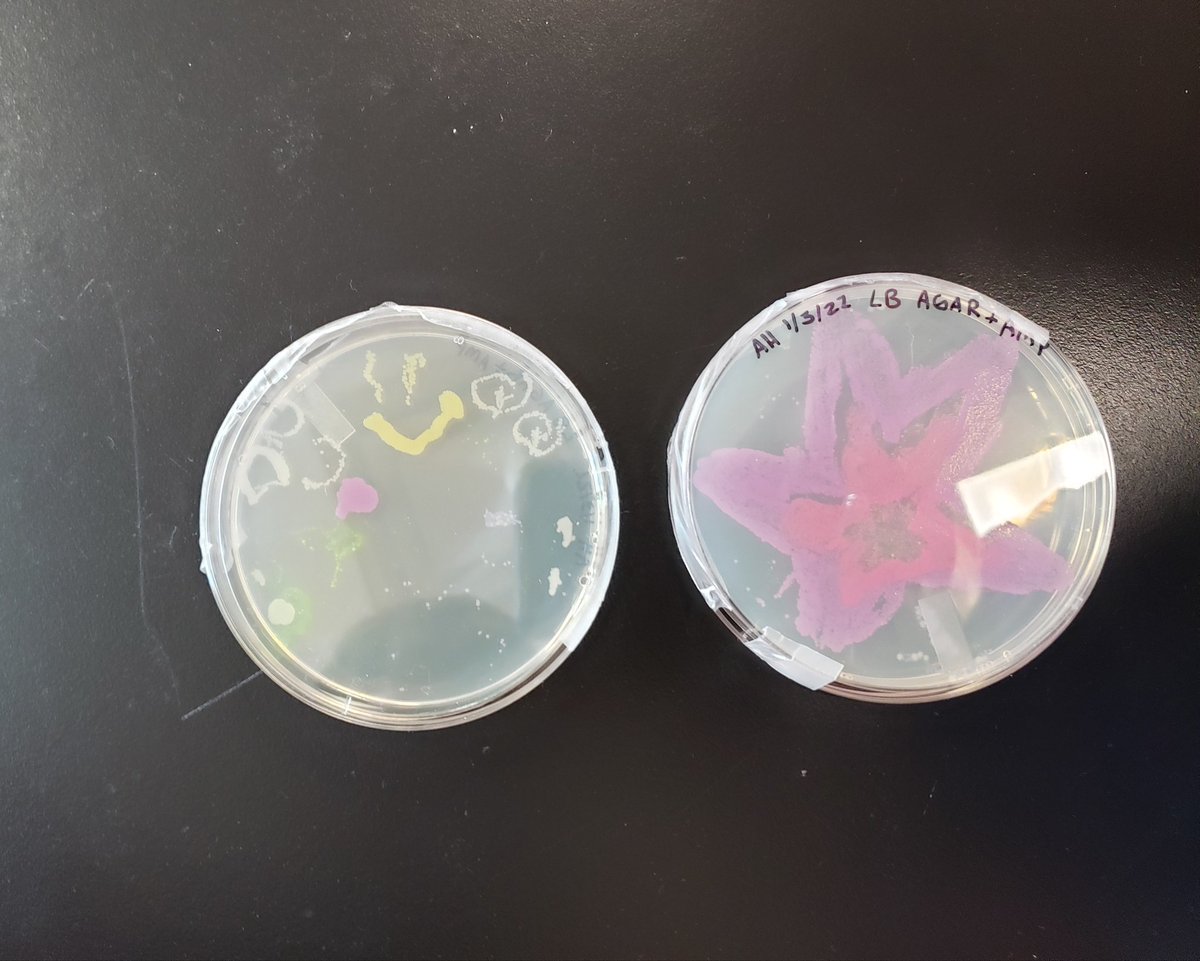
Painting with bacteria. Science + Art ❤
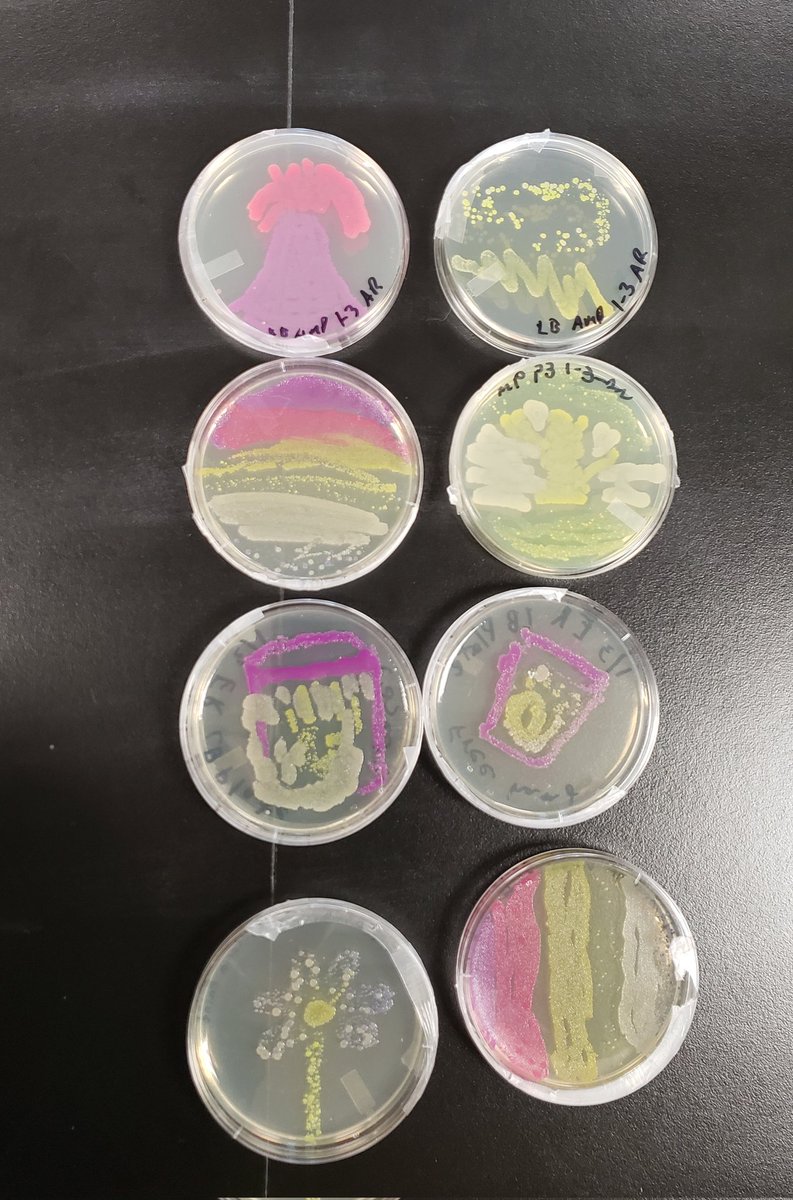
Our art is growing up real nice

Katy Gazda
@mssgazda
Mom to Sam. MamaNerd to the rest of my children. Letting go of the fear that I am powerful beyond measure (M. Williamson)
ID: 983752563894792192
10-04-2018 17:04:23
1,1K Tweet
149 Takipçi
84 Takip Edilen




Today was Koa's first day on campus as an official therapy dog with Mesa Public Schools Pawsitive Peers program. It was hard too tell who enjoyed it more, Koa or everyone who loved on her.